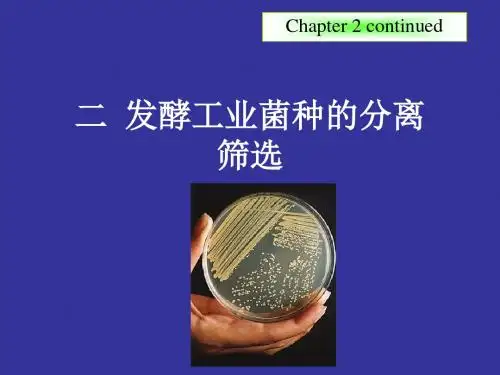

样品充分混匀; 每支移液管及涂布棒只能接触 一个稀释度的菌液;
同一稀释度三个以上重复,取平 均值;
每个平板上的菌落数目合适, 便于准确计数;
①初筛
初筛是从分离得到的大量菌种中将合成目的产物的菌种筛 选出来的过程。初筛可分为两种情况进行:
a.平板筛选 对于在分离纯化阶段没有进行平板定性法挑选 出来的菌株,可以先进行平板定性筛选。在初筛时,使 用平板快速检测法,将复杂而费时的化学测定改为平板 上肉眼可见的显色或生化反应,可以减少筛选的工作量, 大幅度地提高筛选效率。
研究方法 1、模拟自然培养法:原位培养、培养条件优化、单细胞操作。
2、宏基因组分析法:测序分析未培养微生物的基因组,结合蛋白质组学, 了解其代谢途径、基因表达调控机制等。
第二节 发酵工业菌种的分离筛选
菌种的来源
根据资料直接向有科研单位、高等院校、工厂或菌种保 藏部门索取或购买;
从大自然中分离筛选新的微生物菌种。
度、碳源和氮源类型及浓度等,使目的微生
物在最适宜条件下迅速繁殖,数量增加,成
为人工环境下的优势种。
3. 富集培养
富集培养的策略 (1)控制培养基的营养成分 用促进某特定微生物生长繁殖的选择性培养基或培养条件。 可用抑制其他微生物生长繁殖的选择性培养基或培养条件。
例如碳源利用的控制,可选定糖,淀粉、纤维素,或者石油等,以其中的一种为唯一碳源,那么只有 利用这一碳源的微生物才能大量正常生长,而其它微生物就可能死亡或淘汰。这样对下阶段的纯 种分离就会顺利得多。
在科学研究中,通过菌种选育还可以了解菌种的 遗传学性质
2.1 工业发酵菌种概述
10
1
微生物物种
100 已发现物种
被利用物种
细菌